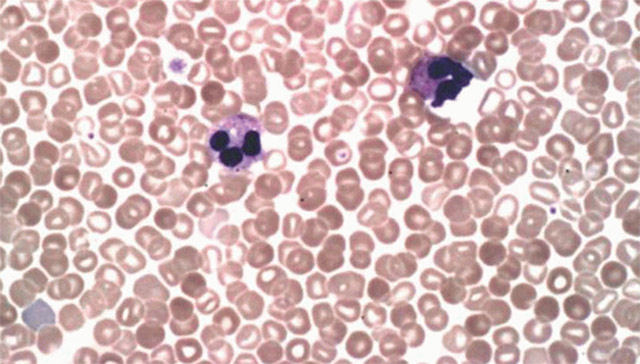

Причины и разновидности эритроцитоза
При эритроцитозе, независимо от его происхождения, наблюдается увеличение количества эритроцитов, что приводит к повышению уровня гематокрита. В некоторых случаях фиксируется рост других клеток крови, что может указывать на нарушения в костном мозге, например, при болезни Вакеза.
Для правильной интерпретации результатов анализа крови необходимо знать нормальные значения, которые различаются для взрослых и детей, а также для мужчин и женщин. Верхний предел нормы гематокрита составляет 0,48 у мужчин и 0,47 у женщин. Количество эритроцитов не должно превышать 5,5×10^12/л у мужчин и 5,0×10^12/л у женщин, а уровень гемоглобина — 164 г/л и 172 г/л соответственно. Масса эритроцитов на килограмм веса не должна превышать 36 мг у мужчин и 32 мг у женщин.
На основе результатов гематологического анализа врач определяет, имеется ли повышение уровня эритроцитов, и, если да, выясняет его причину. Важно понять, связано ли это с истинным увеличением количества красных кровяных клеток в организме или с относительным увеличением, вызванным перераспределением клеточной массы и объема плазмы.
- Первичный — увеличение числа клеток происходит из-за активной продукции в костном мозге, часто причиной являются генетические мутации.
- Вторичный — указывает на наличие другой болезни, проявляющейся гипоксией, обезвоживанием и другими факторами.
- Абсолютный — наблюдается рост общего числа циркулирующих эритроцитов в крови.
- Относительный — количество красных кровяных клеток остается в пределах нормы, но наблюдается дефицит жидкой части крови.
Об относительном эритроцитозе говорят, когда количество эритроцитов не увеличивается, но объем плазмы уменьшается. В этом случае общее количество клеток в кровеносной системе остается нормальным, однако из-за сгущения крови, вызванного потерей жидкости, появляются лабораторные признаки эритроцитоза. Относительный эритроцитоз чаще всего имеет вторичный характер и не связан с патологией самих эритроцитов или тканей, отвечающих за кроветворение.
Причины относительного эритроцитоза могут включать:
- Потерю жидкости при обезвоживании, вызванном приемом мочегонных средств, кишечными инфекциями с диареей и рвотой.
- Ожоговую болезнь.
- Артериальную гипертензию.
- Синдром Гайсбека, проявляющийся гипертензией, избыточным весом и тревожными расстройствами.
Абсолютный эритроцитоз характеризуется увеличением абсолютного числа красных кровяных клеток в единице объема крови. Этот процесс свидетельствует о повышенной активности костного мозга, где образуется и созревает избыточное количество клеток, причем их зрелость может быть недостаточной, что указывает на опухолевую природу заболевания. Причины абсолютного эритроцитоза:
- Истинная полицитемия.
- Наследственный эритроцитоз.
Первичный эритроцитоз — это состояние, связанное с нарушениями в процессе кроветворения и самих эритроцитов. Он может возникнуть в результате генетических мутаций или воздействия канцерогенов на стволовые клетки костного мозга. К этой категории относятся:
- Эритремия — истинная полицитемия или болезнь Вакеза, имеющая опухолевую природу и сопровождающаяся избыточной продукцией эритроцитов костным мозгом.
- Первичный эритроцитоз, вызванный аномалиями рецепторов (наследственного характера), когда красные клетки чрезмерно чувствительны к стимуляторам их пролиферации (эритропоэтину).
Вторичный эритроцитоз возникает при увеличении секреции эритропоэтина, который стимулирует образование красных клеток в костном мозге. Это может происходить в ответ на гипоксию:
- При хронической дыхательной недостаточности (абсцессы легких, туберкулез, хронический бронхит, бронхиальная астма, эмфизема и др.).
- При сердечных пороках, приводящих к сбросу венозной крови в артериальное русло (врожденные дефекты перегородок и крупных сосудов).
- При снижении вентиляции легких у людей с выраженным ожирением или поражениями головного мозга.
- У жителей высокогорья и альпинистов, находящихся в условиях недостатка кислорода.
- У курильщиков.
- У людей, принимающих андрогены в лечебных целях.
Также вторичный эритроцитоз может быть вызван повышением концентрации эритропоэтина из-за:
- Почечных заболеваний — опухолей, кист, состояний после пересадки почки, гидронефротической трансформации, поликистоза, сужения почечных артерий.
- Рака печени.
- Опухолей мозжечка.
Редкими причинами вторичного эритроцитоза являются миома матки и злокачественные новообразования яичников, а также феохромоцитома. Вторичный эритроцитоз может быть как абсолютным, так и относительным, в то время как первичный обычно представляет собой истинное увеличение количества эритроцитов в крови.
Эритроцитоз представляет собой состояние, характеризующееся повышением уровня эритроцитов в крови. Врачи отмечают, что это может быть вызвано различными факторами, включая хронические заболевания легких, сердечно-сосудистые патологии или высокую физическую активность. Существует два основных вида эритроцитоза: первичный, связанный с мутациями в клетках костного мозга, и вторичный, возникающий в ответ на гипоксию или другие внешние факторы.
Диагностика включает общий анализ крови, который позволяет определить уровень гемоглобина и количество эритроцитов. Важно учитывать, что течение заболевания может варьироваться: у некоторых пациентов оно протекает бессимптомно, в то время как у других могут возникать осложнения, такие как тромбообразование. Врачи подчеркивают необходимость своевременного выявления и лечения эритроцитоза для предотвращения серьезных последствий.

Какие обследования понадобятся для диагностики эритроцитоза?
При выявлении повышенного уровня эритроцитов необходимо провести дополнительные исследования для установления причины изменений. Врач осматривает пациента, уточняет список принимаемых медикаментов и выясняет наличие ранее перенесенных заболеваний и операций.
Лабораторная диагностика эритроцитоза включает:
- Общий анализ крови с определением клеточного состава. Возможно повышение только эритроцитов или других клеток, происходящих из белого ростка кроветворения (лейкоцитов, эозинофилов), а также тромбоцитов.
- Анализ газового состава крови. Чем ниже уровень кислорода или выше содержание карбоксигемоглобина (например, у курильщиков), тем более выражен эритроцитоз.
- Измерение массы эритроцитов и объема плазмы крови.
- Определение уровня эритропоэтина. Хотя этот показатель не всегда надежен, его следует оценивать в комплексе.
После лабораторных исследований могут быть назначены УЗИ или КТ органов брюшной полости для более детального изучения состояния почек. При необходимости проводится обследование других органов в зависимости от предположений врача. В случае подозрения на первичную эритремию может быть полезна трепанобиопсия костного мозга для уточнения диагноза.
| Показатель | Описание | Примечания |
|---|---|---|
| Понятие эритроцитоза | Увеличение количества эритроцитов в единице объёма крови выше референсных значений. | Различают относительный и абсолютный эритроцитоз. |
| Причины эритроцитоза (абсолютный) | • Первичный (полицитемия vera): миелопролиферативное заболевание костного мозга. • Вторичный: ◦ Гипоксия (высотная болезнь, заболевания легких, сердечно-сосудистой системы, курение). ◦ Повышенное образование эритропоэтина (почечная недостаточность, опухоли, прием анаболических стероидов). |
Абсолютный эритроцитоз характеризуется увеличением массы эритроцитов. |
| Причины эритроцитоза (относительный) | Обезвоживание организма (потеря жидкости, диарея, рвота). | Относительный эритроцитоз – увеличение концентрации эритроцитов за счет уменьшения объема плазмы крови, масса эритроцитов при этом не увеличена. |
| Виды эритроцитоза | • Первичный (истинный) эритроцитоз (полицитемия vera). • Вторичный (симптоматический) эритроцитоз. • Относительный эритроцитоз. |
Классификация основана на причинах развития. |
| Диагностика эритроцитоза | • Клинический анализ крови (гематокрит, количество эритроцитов, гемоглобин). • Биохимический анализ крови (креатинин, мочевина, электролиты). • Газовый состав артериальной крови. • Исследование костного мозга. • Генетические исследования (при подозрении на полицитемию vera). |
Диагностика направлена на выявление причины эритроцитоза. |
| Особенности течения эритроцитоза (первичный) | • Прогрессирующее увеличение количества эритроцитов, лейкоцитов и тромбоцитов. • Увеличение селезенки. • Риск тромбозов и кровотечений. • Симптомы: головная боль, головокружение, слабость, зуд кожи, покраснение лица. |
Требует специфического лечения. |
| Особенности течения эритроцитоза (вторичный) | Зависит от основной причины. Может протекать бессимптомно или проявляться симптомами основного заболевания. | Лечение направлено на устранение причины. |
| Особенности течения эритроцитоза (относительный) | Как правило, проходит после устранения причины обезвоживания. | Не требует специфического лечения. |
Рисунок: базовая принятая диагностика эртироцитоза по уровню эритропоэтина
Эритроцитоз — это состояние, характеризующееся повышением уровня эритроцитов в крови, что может привести к увеличению вязкости крови и, как следствие, к различным осложнениям. Люди часто обсуждают причины этого явления, которые могут быть как первичными, так и вторичными. Первичный эритроцитоз, например, связан с мутациями в клетках костного мозга, тогда как вторичный может возникать из-за хронической гипоксии, например, при заболеваниях легких или на высоких высотах.
Диагностика включает анализы крови, которые помогают определить уровень гемоглобина и количество эритроцитов. Важно отметить, что симптомы могут быть неявными, и многие пациенты не подозревают о наличии проблемы. Часто эритроцитоз протекает бессимптомно, но в некоторых случаях может вызывать головные боли, головокружение и повышенную утомляемость. Лечение зависит от причины и может включать флеботомию, медикаментозную терапию или коррекцию образа жизни.

Первичный эритроцитоз
Симптоматический эритроцитоз (вторичный) является проявлением другой болезни, которая определяет его причины, симптомы и методы лечения. В отличие от него, первичное увеличение эритроцитов представляет собой самостоятельное заболевание с уникальными причинами и клиническими проявлениями. Поэтому стоит рассмотреть его более подробно.
Болезнь Вакеза
Наиболее распространенной причиной первичного абсолютного эритроцитоза является болезнь Вакеза, также известная как полицитемия. Это заболевание относится к хроническим опухолевым процессам в костном мозге и характеризуется избыточным образованием клеток всех трех линий кроветворения — эритроцитов, тромбоцитов и лейкоцитов. В результате увеличивается объем циркулирующей крови и размер селезенки.
Эритроцитоз чаще всего наблюдается у пожилых людей, причем у мужчин заболевание встречается несколько чаще. Хотя болезнь является относительно редкой (примерно 5 случаев на миллион населения в год), она привлекает внимание из-за высокой вероятности тромбообразования, кровотечений и риска трансформации полицитемии в острые лейкозы.
К основным причинам болезни Вакеза относятся:
- Спонтанные мутации в стволовых клетках, приводящие к образованию аномальных клонов клеток крови, не реагирующих на эритропоэтин.
- Генетическая предрасположенность — среди еврейского населения зафиксированы семейные случаи заболевания.
Аномальные красные кровяные клетки, формирующиеся в костном мозге, размножаются бесконтрольно, так как не подвержены влиянию эритропоэтина, что делает их основным источником эритремии.
Абсолютный эритроцитоз при болезни Вакеза приводит к изменению вязкости крови (ее сгущению), повышению свертываемости и нарушению структуры печени и селезенки. У пациентов с повышенной вязкостью крови наблюдается склонность к тромбообразованию, что вызывает гипоксию тканей и застой крови. Перегрузка красного костного мозга может привести к его истощению, ухудшению структуры и фиброзу.
Истинный эритроцитоз развивается постепенно и на ранних стадиях может быть выявлен случайно. Первые признаки эритремии включают:
- Тяжесть и шум в голове;
- Головокружение;
- Проблемы со зрением;
- Охлаждение кожи на конечностях;
- Нарушения сна.
Эти симптомы могут напоминать проявления других заболеваний, таких как артериальная гипертензия, и поэтому долгое время могут оставаться незамеченными, особенно у пожилых людей. С увеличением объема циркулирующей крови и числа клеток в ней появляются признаки полнокровия:
- Красный оттенок кожи, особенно на открытых участках тела;
- Расширенные капилляры и мелкие кровоизлияния на коже;
- Покраснение склер из-за расширенных сосудов;
- Синюшность мягкого неба при нормальном цвете твердого;
- Зуд кожи;
- Покраснение, болезненность и жжение в кончиках пальцев.
На запущенных стадиях заболевания пациенты страдают от сильных головных болей, болей в костях и сердце, повышенного артериального давления, кровоточивости десен и кожных гематом. При осмотре может быть обнаружена увеличенная селезенка, реже — печень. Повышение вязкости крови из-за эритроцитоза способствует образованию микротромбов и трофическим расстройствам в коже и слизистых оболочках пищеварительного тракта.
Среди осложнений можно выделить тромбозы мозговых артерий и инсульты, инфаркт миокарда, тромбоэмболию легочной артерии, а также кровотечения из желудка или кишечника. В крови пациентов с первичной эритремией наблюдается эритроцитоз и повышенный уровень гемоглобина, а также увеличение числа лейкоцитов и тромбоцитов, что не всегда фиксируется при вторичном эритроцитозе.

Вторичный эритроцитоз
При вторичном эритроцитозе увеличение количества красных кровяных клеток происходит в результате адаптации организма к нехватке кислорода или различных патологий. К ним относятся избыток факторов, стимулирующих образование эритроцитов, сгущение крови, стрессовые состояния и эндокринные расстройства. Классификация вторичных эритроцитозов сложна и включает множество состояний, приводящих к повышению уровня эритроцитов.
Стрессовые эритроцитозы возникают из-за поступления в кровоток избыточного количества клеток из запасов. Причинами могут быть:
- Сильные эмоциональные переживания и стрессы;
- Хроническая бессонница;
- Интенсивные физические нагрузки;
- Гипертонические кризы.
Эти факторы вызывают выброс адреналина и других биологически активных веществ, которые воздействуют на рецепторы селезенки, приводя к ее сокращению и выбросу хранящихся в ней красных кровяных клеток в периферическую кровь. Этот тип вторичного эритроцитоза обратим и может исчезнуть со временем.
Гемоконцентрационный вторичный эритроцитоз возникает из-за потери жидкости или перемещения жидкости из сосудов в ткани. Он считается относительным, так как общее количество клеток не меняется. Причинами могут быть:
- Чрезмерное потоотделение (работа в жарких условиях, длительное пребывание на солнце без воды, высокая температура);
- Понос и рвота при заболеваниях органов пищеварения, кишечных инфекциях, опухолях мозга;
- Кетоацидоз у диабетиков;
- Ожоги;
- Обширные язвы и некротические поражения кожи.
Легочный вторичный эритроцитоз — одна из наиболее распространенных форм, возникающая при заболеваниях органов дыхания. Он относится к абсолютным эритроцитозам, так как наблюдается увеличение общего числа эритроцитов. Это состояние является естественным адаптационным процессом в ответ на недостаток кислорода.
Основные механизмы легочного эритроцитоза связаны со снижением кислородной насыщенности крови, гипоксическими изменениями в тканях, повышенным синтезом эритропоэтина и активизацией созревания большого количества эритроцитов. Он может возникать при:
- Хронических обструктивных заболеваниях бронхов;
- Бронхиальной астме;
- Эмфиземе;
- Состоянии после удаления значительной части легочной ткани;
- Ателектазах легкого;
- Пневмосклерозе;
- Спайках в грудной полости;
- Выпотном плеврите;
- Опухолях легких;
- Пневмокониозах (например, асбестоз);
- Стенозе легочной артерии и ее ветвей.
Лабораторные изменения при легочном эритроцитозе характеризуются высоким уровнем эритроцитов и повышением гемоглобина (до 10х10^12/л и более эритроцитов и до 250 г и более гемоглобина на литр крови). Из-за значительного сгущения крови скорость оседания эритроцитов (СОЭ) может быть равна нулю.
Самостоятельной причиной симптоматического эритроцитоза считается увеличение доли карбоксигемоглобина в крови на фоне гипоксических процессов в тканях. Уровень эритроцитов будет еще выше, если курильщик страдает хроническим бронхитом или ожирением.
Созревание клеток в костном мозге регулируется гормонами, поэтому среди вторичных эритроцитозов важное место занимают различные патологии. Умеренное увеличение количества эритроцитов наблюдается при заболеваниях щитовидной железы, включая рак, патологиях надпочечников (гиперальдостеронизм, синдром Иценко-Кушинга, феохромоцитома), гипофиза, а также у мужчин с новообразованиями в семенниках и у женщин с патологиями яичников (кисты, туберкулез).
Дисциркуляторные эритроцитозы возникают на фоне заболеваний сердца и сосудов — врожденных пороков сердца с сбросом венозной крови в артериальный круг, патологиях легочной артерии, хронической легочно-сердечной недостаточности. Они часто встречаются у новорожденных с тяжелыми врожденными аномалиями сердца.
«Почечный» эритроцитоз — еще одна распространенная форма нарушения количества эритроцитов. Гипоксия почечной паренхимы, возникающая при заболеваниях почек, приводит к выбросу эритропоэтина и увеличению образования красных клеток в костном мозге. Причинами могут быть новообразования (как злокачественные, так и доброкачественные), поликистоз, гидронефроз, сосудистые пороки почек, а также перенесенная пересадка органа.
Среди более редких причин вторичного эритроцитоза можно выделить новообразования поджелудочной железы, рак печени, тромбоз печеночных вен, язвы желудка и 12-перстной кишки, миому матки, поражения селезенки, гемангиобластому мозжечка и даже профессиональные вредности. Известно, что количество эритроцитов увеличивается при работе с марганцем, в условиях повышенной вибрации, а также в загрязненном угольной пылью или песком воздухе.
Эритроцитоз может возникать и у детей. Наиболее распространенными предрасполагающими факторами для повышения уровня эритроцитов и гемоглобина являются врожденные пороки сердца, легочные заболевания и нарушения функции почек. Часто диагностируется генетическая предрасположенность к данной патологии.
Эритремия с гиперплазией клеток костного мозга, увеличением числа тромбоцитов и лейкоцитов у детей встречается редко. С первых дней жизни в крови наблюдается повышение уровня гемоглобина, который может достигать 200 г/л и более. Симптомами эритроцитоза могут быть судороги, острая дыхательная недостаточность, учащение пульса, желтуха и сердечная недостаточность. Новорожденные с синдромом Дауна и Беквита, а также имеющие низкий вес при рождении, более подвержены этому состоянию. Причина такого явления часто остается неясной.
Лечение эритремий зависит от их причин. При вторичном повышении уровня эритроцитов на фоне заболеваний внутренних органов или эндокринных желез терапия направлена на устранение основной патологии. Курильщикам с эритроцитозом рекомендуется отказаться от вредной привычки, а людям с избыточным весом — принять меры по снижению массы тела.
Первичная эритремия лечится кровопусканием, эритроцитаферезом и назначением цитостатиков. Для нормализации вязкости и свертываемости крови применяются гепарин, аспирин и курантил. Малышам с первичным эритроцитозом также могут проводить кровопускание, но с осторожностью из-за высокого риска развития анемии.
Видео: лекция об эритроцитозах
Видео: полицитемия – первичный эритроцитоз, программа “Жить здорово!”
Вопрос-ответ
Что такое эритроцитоз?
Эритроцитоз — это повышение выработки красных клеток крови (эритроцитов). См. также общие сведения о миелопролиферативных новообразованиях.
Что может быть причиной повышения эритроцитов в крови?
Основные причины повышения уровня эритроцитов: гипоксия, заболевания почек, эндокринные заболевания, эритремия — хроническая болезнь, при которой костный мозг вырабатывает слишком много красных кровяных телец, а также состояния, связанные со значительной потерей жидкости (кишечные инфекции, ожоги, кетоацидоз).
Как можно бороться с эритроцитозом?
Борьба с эритроцитозом включает в себя выявление и лечение основной причины его возникновения, что может включать коррекцию гипоксии, лечение заболеваний легких или сердца, а также прекращение курения. В некоторых случаях может потребоваться флеботомия (удаление крови) для снижения уровня эритроцитов, а также применение медикаментов для снижения продукции эритроцитов. Важно также следить за уровнем гидратации и избегать факторов, способствующих повышению эритроцитов.
Какая опухоль вызывает эритроцитоз?
Эритроцитоз, обусловленный опухолевым процессом, может возникать в случае секреции эритропоэтина опухолями почек, кистами, гематомами, гемангиобластомами мозжечка или лейомиомами матки.
Советы
СОВЕТ №1
Обратите внимание на симптомы. Если вы замечаете у себя такие признаки, как головные боли, усталость, покраснение кожи или затрудненное дыхание, не откладывайте визит к врачу. Эти симптомы могут указывать на эритроцитоз и требуют медицинского обследования.
СОВЕТ №2
Регулярно проходите медицинские обследования. Анализы крови помогут контролировать уровень эритроцитов и выявить возможные отклонения на ранних стадиях. Это особенно важно для людей с предрасположенностью к заболеваниям крови.
СОВЕТ №3
Обратите внимание на образ жизни. Здоровое питание, регулярные физические нагрузки и отказ от курения могут помочь поддерживать нормальный уровень эритроцитов и снизить риск развития эритроцитоза. Убедитесь, что ваш рацион богат витаминами и минералами.
СОВЕТ №4
Консультируйтесь с врачом по поводу лечения. Если у вас уже диагностирован эритроцитоз, следуйте рекомендациям врача и не занимайтесь самолечением. Правильное лечение может варьироваться в зависимости от причины заболевания, поэтому важно получать профессиональную помощь.